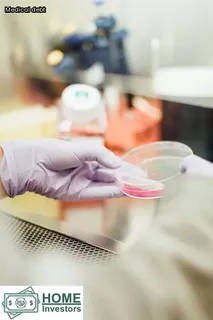
Debt

Hospitals may be able to place a lien on your home in Florida if you fail to pay your medical bills. A lien is a legal claim that allows the hospital to take ownership of your property until the debt is paid in full.
When a hospital places a lien on your home, it can interfere with your ability to sell or refinance the property until the debt is settled. To protect yourself from this type of situation, it’s important to understand how hospital liens work and what you can do.
In most cases, hospitals must notify you before placing a lien on your property by sending you a “Notice of Lien” document. This document will explain how much money you owe and what steps must be taken in order to resolve the debt.
Once you receive the notice, it’s important to speak with an attorney who specializes in medical liens right away. An attorney can help negotiate with the hospital for lower payments or payment plans so that you don’t have to worry about losing your home due to unpaid medical bills.
Additionally, some hospitals may be willing to accept health insurance coverage as payment for outstanding medical debts which could potentially reduce or eliminate the need for placing a lien on your home. It’s also important to make sure that any payments made are documented properly so that there is no confusion about what was paid and when it was paid.

Paying medical bills is an important responsibility for any person. If a hospital in Florida does not receive payment for services provided, they may place a lien on the patient's property.
This means that the hospital will be able to take legal action against the property and gain partial or full ownership if the bill remains unpaid. Liens can cause serious financial hardship and put homeowners in a difficult position.
It is important to understand the consequences of unpaid medical bills so that you can stay on top of payments and avoid liens on your home. Seeking professional advice or help from organizations that provide assistance with medical debt can help ease the burden and keep your property safe from potential liens.
If a hospital in Florida has placed a lien on your home, it is important to understand what this means and what options you have. A lien gives the hospital the legal right to take possession of your property if you fail to pay your medical bills.
It's important to act quickly and responsibly if you find yourself unable to pay off your medical debt. You should contact the hospital or creditor as soon as possible to explain your financial circumstances and negotiate payment arrangements that fit within your budget.
Additionally, some hospitals offer charity care or other discount programs for those unable to pay their medical bills in full. If you cannot afford to make payments, it may be possible to set up an installment plan with the hospital or creditor so that you can pay off the debt over time.
Lastly, if all else fails, bankruptcy may be an option for eliminating medical debt in Florida. Knowing the options available can help you manage your medical debt and protect your home from being taken away by a lien.

When a hospital places a lien on your home or property in Florida, they are essentially creating a legal claim against it. This means that the hospital has an interest in the property, and if you were to sell it, they would have the right to recoup any money owed to them.
In order to place a lien, the hospital must file paperwork with the appropriate court and register their claim against your home. The lien will remain in place until you pay off the debt or come up with an arrangement with the hospital.
In some cases, liens can be removed after certain conditions are met. For example, if you can prove that you paid off the debt or entered into an agreement with the hospital, then they may agree to remove their lien.
It is important to understand how liens work and what options are available for dealing with them if you find yourself in this situation.
Hospitals have the right to place a lien on a property in Florida when they are owed money for services provided. This type of lien is known as a hospital lien, and it is important to understand how these liens work and what options are available to protect yourself.
A hospital lien is not the same as a mortgage or home equity loan; instead, it is an encumbrance placed on property that prevents it from being sold or refinanced until the debt to the hospital has been paid. Generally, if you do not pay your medical bills, the hospital can put a lien on your home in order to secure payment.
Once the debt has been satisfied, then the lien must be released. If you are facing this situation, you may want to seek legal advice about how best to deal with it.
In some cases, bankruptcy may provide an avenue for resolving the debt without losing your home. It is also important to note that hospitals cannot place liens on certain types of property such as homesteads and other exempt items; however, they can still place liens on any improvements made to those properties such as additions or garages.
Understanding how hospital liens work in Florida can help you make informed decisions about your finances and protect your assets.

Medical debt can be a stressful and overwhelming financial burden, but it doesn't have to end in a lien being placed on your home. In the state of Florida, it is possible for hospitals to place a lien on your house if you don't pay medical bills.
To avoid this situation, it is important to understand how medical liens work and take action to protect yourself from having one placed on your home. Start by becoming familiar with the laws specific to Florida that regulate how medical liens are enforced.
Review any outstanding bills you owe as soon as possible and contact the hospital or healthcare provider to negotiate an affordable payment plan. If you cannot pay off the debt in full or make payment arrangements, consider hiring a lawyer who specializes in medical debt law to help you explore options such as bankruptcy protection or loan consolidation.
Finally, if the hospital threatens to place a lien on your home, consult with a qualified legal professional to determine what steps you should take next. By taking these precautionary measures, you can protect yourself and your family from having a medical debt lien placed on your house in Florida.
The issue of a lien attached to a house can be daunting, especially when selling. In Florida, it is possible for a hospital to place a lien on a home if the owner's debts are not paid in full.
This could present some challenges when trying to sell the property. On the one hand, it is important for the seller to ensure that all liens are properly discharged before closing on the house so that no financial obligations remain.
However, this process may take time and money which could delay the sale of the property. On the other hand, if a lien is not cleared from the title prior to sale, it could cause buyers to end negotiations or require additional paperwork and fees during closing.
Furthermore, if payments have not been made on any outstanding debt attached to the property, it could affect its value since potential buyers will see it as an added cost or burden they would need to take on. Therefore, understanding both sides of this situation can help sellers make informed decisions when considering selling their home with an unpaid lien attached.

It is possible to remove a hospital lien from your property in Florida. The process of removing a hospital lien from a home can be complex and involve multiple steps, including filing documents with the court, paying off any outstanding debts, and ultimately obtaining a release of the lien.
Depending on the type of lien placed on your home, it may be necessary to contact the hospital or its collection agency to resolve the issue. It is important to note that if you are unable to pay off the debt in full, some hospitals may accept a settlement amount that is less than what was originally owed.
Additionally, if you believe that the hospital has unfairly placed a lien on your property in error, it may be possible to dispute the claim and have it removed. Understanding how liens work can help you decide which option is best for you and ensure that you are able to remove any liens from your property in Florida as quickly as possible.
Navigating the legalities of unpaid medical debt and liens can be a daunting process. In Florida, hospitals may be able to place a lien on an individual's home if there is an issue with unpaid medical bills.
The specifics vary from state to state, but in general, when a hospital places a lien on a property for unpaid medical bills, it gives them the right to take ownership of that property if the bill still goes unpaid. In order to avoid this situation, it is important to understand how this process works and if it applies in your particular situation.
To protect yourself from having a lien placed on your property, it's important to stay up-to-date on payments and communicate with the hospital about any issues you may have with paying your bill. It's also important to know the specific laws regarding liens in your particular state so you can make sure you are taking all necessary steps to protect your home.

When a creditor attempts to place a lien on a property in Florida, they have certain rights that must be respected. In order for the lien to be enforceable, it must first be properly recorded with the local county government.
Once the lien has been recorded, the creditor has the right to pursue collection of any debt owed by seizing any assets or money owned by the debtor. Additionally, creditors may garnish wages, levy bank accounts, and even attempt to foreclose on a home if necessary.
A hospital can legally place a lien on your house in Florida if you fail to pay medical bills in a timely manner. In some cases, creditors can also place liens against personal property such as cars or boats in order to secure payment on any outstanding debts.
It's important to note that placing liens is an extreme measure that creditors often take only as a last resort after other collection efforts have failed.
In Florida, hospitals that provide medical care have the ability to place a lien on a patient's real property in order to secure payment for services rendered. This law is outlined in the state's Statute 713.
It states that any hospital providing emergency or non-emergency medical care may legally place a lien on any real estate owned by a patient when they are unable to make payment for their treatment. The lien is placed against any real property owned by the patient, including homes, commercial buildings, and land.
The lien remains until it has been paid in full or until the hospital agrees to release it. When a hospital places a lien on a property, the owner cannot sell or transfer ownership of the property without first satisfying the debt associated with the lien.
In addition to placing liens, hospitals may also take other legal action against patients who fail to pay for their medical treatment such as filing suit in court or garnishing wages from employment income.

Medical debt can have a significant impact on credit scores, as unpaid medical bills can lower the score. It is important to understand how hospitals handle unpaid medical bills and what options are available if a person cannot pay.
In the state of Florida, hospitals may place a lien on a home in order to collect payment for medical debt. This lien affects both the borrower's ability to obtain or refinance other loans using their home as collateral, and it could also appear on their credit report affecting their credit score.
Credit reports usually include any liens placed by hospitals, even if they have been paid off, making it difficult for people with past medical debt to improve their credit score. It is therefore essential to be aware of all options available to pay off any medical debts before the hospital takes further action.
When a hospital places a lien on a person's home in Florida, it can be a difficult financial burden to bear. Fortunately, there are alternatives available that may help individuals avoid this situation.
If the person owes money to the hospital, they may be able to negotiate with them for reduced payments or an extended payment plan to pay off the debt over time. Additionally, they may be able to find outside sources of funding such as grants, scholarships, or loans.
It may also be possible to refinance their mortgage and use the equity in their home as collateral to pay off the debt. Ultimately, it is important for those facing medical bills in Florida to explore all of their options before agreeing to have a lien placed on their home.

Changes to hospital lien law in Florida have been occurring frequently as of late. Property owners should stay informed of their rights and obligations if they are ever faced with a hospital lien on their home.
A hospital lien can be placed on any property owned by someone who has received medical care from that hospital, and is used as a way for the hospital to recoup costs if the patient is unable to pay their medical bills. In order to place a lien on real property, such as a house or land, the hospital must first file a claim with the court and receive an order permitting them to do so.
It is important for homeowners to understand that once a lien has been placed on their home, it cannot be removed until all outstanding medical bills have been paid off. If you find yourself in this situation, consulting with an experienced attorney can help ensure you are aware of your rights and options when it comes to dealing with these liens.
Knowing how to navigate these laws can help protect you from potential financial hardship due to unpaid medical bills. Keeping up with changes in Florida's hospital lien law can help keep your assets secure and provide peace of mind during an otherwise stressful time.
Facing medical debt can be a daunting task, and the thought of a hospital placing a lien on your home in Florida can be stressful. However, understanding asset protection strategies to protect yourself from medical debt is essential.
One way to protect your assets is to create an LLC or other legal entity that owns your property. This prevents creditors from seizing personal assets when trying to collect unpaid debts.
Additionally, transfer ownership of all high-value assets, such as cars and jewelry, into the name of a trust or family member. These transfers will protect them from being seized by creditors.
Moreover, you can avoid liens on properties by filing for bankruptcy if you’re unable to pay the debt. Bankruptcy will stop all collection activity and prevent any additional debt from accruing.
Furthermore, you should review state laws concerning allowable exemptions for medical debtors as they vary by state; some states may allow certain assets to remain exempt from creditor claims even after declaring bankruptcy. Lastly, speaking with an experienced attorney who specializes in asset protection may also provide valuable insight into how best protect yourself against potential liens in Florida.
When a medical bill is unpaid, hospitals can place a lien on real estate in the state of Florida. This article will offer an overview of common questions regarding hospital liens, provide conflict resolution for those facing real estate liens, explain when it is wise to place a lien on someone’s house and suggest solutions for unpaid medical bills without going to court.
Additionally, tips will be offered to protect one’s most valuable asset from medical debt. Liens are legal claims against property but they can also be expensive and time-consuming for both the debtor and creditor.
A hospital lien is only placed after all other payment options have been exhausted. When determining if it is wise to place a lien on someone’s house, factors such as the amount of debt owed and the value of their home should be considered.
It may be better in some cases to negotiate with the debtor rather than resorting to a legal battle which can take years to resolve. Alternatives such as payment plans or financial aid may provide relief for those struggling with medical bills.
Furthermore, protecting one’s assets from medical debt can be done by using insurance or setting aside funds in case of emergencies. Medical debt should not have to result in financial ruin; proper planning ahead of time can save you from this burden.
A hospital lien in Florida is a legal document that gives a hospital the right to seize a debtor's property or assets as payment for their medical bill. A lien can be placed on a person’s home, car, wages, bank accounts, investments, and other personal property.
To place a lien on your home in Florida, you must have an unpaid medical bill that is more than 90 days past due. The hospital must also file the lien with the county court where the property is located.
Once filed, the lien will remain active until it is paid off or released by the hospital. After filing the lien with the court, the debtor will receive notice of it and have 30 days to dispute it.
If no dispute is made or if the dispute fails, then the hospital can take legal action to collect its debt from any equity in your home. It’s important to note that not all hospitals in Florida are allowed to place liens on homes and that other states may have different laws regarding hospital liens.

In Florida, a hospital can place a lien on your home. A lien is a legal claim against the property for unpaid debts, and the property cannot be sold or refinanced without settling the debt.
A hospital can place a lien if an individual has not paid medical bills. The hospital must file a civil lawsuit and obtain a court order to put the lien on the property.
The lien will remain until the debt is paid in full and satisfied by the court. Any amount owed to the hospital is subject to interest depending on state laws.
Other creditors can also place liens on properties in Florida, such as mortgage lenders, credit card companies, and other medical providers. Liens may also be placed on any assets owned by someone who owes money in Florida.
It’s important to remember that it’s possible for hospitals in Florida to put a lien on your home for unpaid medical bills.
If you're wondering how to find hospital liens in Florida, there are a few steps you can take. The first step is to contact your local county clerk's office and ask if they have any record of a lien placed on your property from a hospital.
Additionally, you may be able to find out more information about the lien by searching online for any public records related to it. You might also want to check with the state government website for any mention of liens or other legal documents that could pertain to a lien from a hospital.
Finally, you can contact the hospital directly for more information about their lien policy and procedures. Knowing what steps you need to take to find out more information about hospital liens in Florida will help ensure that your rights and interests are protected.
If you have received a lien on your home in Florida, you may be wondering how to dispute it. In the state of Florida, hospital liens can remain in place until the full amount of the debt is paid.
It is important to understand that challenging a lien requires more than simply disputing the amount owed; you must also prove that there was an error or mistake made by either party. To dispute a lien on your property in Florida, start by contacting the hospital and requesting written documentation of the debt.
If there are errors or mistakes present within this documentation, then you should contact an attorney who has experience in dealing with hospital liens and disputes. Additionally, if you believe that an incorrect amount was charged for services rendered, then you can file a complaint with the appropriate government office.
Ultimately, disputing a lien on your property in Florida requires legal knowledge and expertise; it is best to consult with an experienced attorney before taking any action.
A: Yes, hospitals including general hospitals, specialty hospitals, and medical centers may be able to place a lien on your home if you do not pay for your hospitalization expenses.
A: No. A hospital or other healthcare provider is the only entity allowed to place a lien on your home in Florida.
A: Yes, depending on the applicable statutes and laws, it is possible for hospitals in Orlando, Florida to place a lien on your house. They may do so through collection agencies or lawyers.